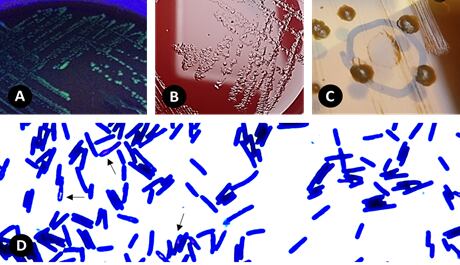

Todo comenzó en 2009, cuando el Hospital San Juan de Dios vivía una de las épocas más desafiantes. La bacteria Clostridium difficile, caracterizada por producir diarreas graves y ser resistente a antibióticos, registró un brote que acabó con la vida de decenas de pacientes y registró al menos 216 casos más de los esperados.
Esta bacteria fue detectada luego en otros hospitales, lo cual motivó a tomar medidas.
En aquel entonces, la Caja Costarricense de Seguro Social (CCSS) no tenía la capacidad para realizar análisis en profundidad, por lo que se alió con la Universidad de Costa Rica (UCR). Los científicos del Laboratorio de Investigación en Bacteriología Anaerobia (LIBA-UCR) se encargaron de confirmar los diagnósticos, así como de la identidad de las cepas circulantes.
Sin embargo, había algo que intrigaba tanto a médicos como a científicos. Varios de los pacientes tenían síntomas muy similares a los generados por la C. difficile, pero las pruebas de laboratorio salían negativas.
Hoy, casi 14 años después se obtuvo la respuesta. Efectivamente, no era esa la bacteria que los había enfermado; no se trataba de cepas que escaparan de las pruebas diagnósticas. No.
Había tres “hermanas” de esta bacteria. Especies completamente distintas, y, además, nuevas para la ciencia.
“Después de repetir las pruebas varias veces, nos dimos cuenta de que las cepas tenían que ser diferentes. Entonces, secuenciamos su genoma (analizaron gen por gen cada una de las muestras)”, comentó en entrevista con la UCR César Rodríguez Sánchez, director del Centro de Investigación en Estudios Tropicales (CIET-UCR).
“Nos percatamos de que, efectivamente, eran tan diferentes que ni siquiera se podrían considerar Clostridium difficile, sino que eran familia y que eran remitidas a nosotros porque causaban un cuadro clínico similar. Resulta que en nuestras manos no tenemos solo una bacteria diferente, eran tres”, añadió.
Para el investigador, este hallazgo contribuyó a demostrar que la diversidad de esas especies cercanas a Clostridium era mayor de lo que se pensaba. Había reportes internacionales que daban cuenta de una bacteria parecida cuando, realmente, existían otras tres más y fueron halladas aquí, en Costa Rica.
Las tres bacterias fueron encontradas en dos hospitales clase A del país, según detallaron los científicos. Los hallazgos fueron reportados en las revistas científicas Scientific Reports e eLife.
Sin embargo, todavía falta algo importante: no tienen nombre. ¿Por qué? El proceso implica depositar esas cepas en colecciones internacionales, de forma que el recurso esté disponible para otros investigadores, con el objetivo de que también puedan estudiarlas.
Además, se debe cumplir una serie de mecanismos legales nacionales e internacionales que están en vías de efectuarse.
LEA MÁS: Hospital San Juan de Dios aísla a cinco pacientes con bacteria peligrosa

LEA MÁS: Hospitales alojan una bacteria mucho más difícil de atacar
¿Cómo son estas bacterias?
Es muy poco lo que se conoce de estas tres nuevas bacterias. Por el momento, está claro que enferman a las personas, pero no se sabe qué tan virulentas o peligrosas para la salud son estas tres especies. Todavía es muy pronto para saber cuán agresivas o letales pueden ser.
También se determinó que provienen del mismo antecesor de la C. difficile. Es decir, son hijas del mismo padre. Sin embargo, aquí viene algo curioso: las especies recién descubiertas son evolutivamente más viejas que la C. difficile, a la que tenemos varias décadas de conocer.
Este trabajo da insumos para mejorar los diagnósticos a nivel nacional e internacional, al tener más certeza científica de que, por un lado, existen estas especies hermanas, pero, por otro, que es un marcador genético específico, indicador de que se trata de una de estas nuevas bacterias, por lo que será más fácil un diagnóstico en futuros pacientes.
“Si hay pacientes muy sugestivos de enfermedades producidas por Clostridium difficile, pero que brinden resultados negativos, ya se sabe hacia dónde pensar. Para estos casos, el equipo de investigación de la UCR está en la capacidad de brindar alternativas diagnósticas, como la prueba de citotoxicidad celular o el cultivo de la bacteria”, afirmó Esteban Chaves, uno de los científicos.
Carlos Quesada, compañero de Rodríguez y de Chaves, aseguró que esto también ayuda a estudiar la resistencia de antibióticos, como ocurre con varias cepas de la C. difficile. Saber de estas nuevas bacterias permitirá dar mejores tratamientos a los pacientes y estudiar más de cerca la resistencia a antibióticos.
LEA MÁS: Brote de bacterias obliga a clausura temporal de Unidad Nacional de Quemados
En estudios internacionales
Estas bacterias también han sido foco de estudio por otros grupos de ciencia del mundo. 18 de ellos, incluyendo científicos de la Universidad de Harvard, pidieron material biológico de estas bacterias a la UCR. Su misión era estudiar si estos nuevos microorganismos cercanos a C. difficile usaban los mismos receptores (sustancias que les permite entrar a la célula humana e infectarla).
Resultó que no. El estudio, publicado en la revista Nature Communications, reveló que las toxinas de las nuevas especies ni siquiera usan los receptores utilizados por la C. difficile para infectar a humanos.
Ellos estudiaron 206 variantes de la toxina B, un componente presente en todas estas bacterias y que en el caso de la C. difficile, da su virulencia y agresividad en los pacientes.
En las nuevas especies vieron que es la misma toxina, pero muy diferente en su comportamiento. Surge la duda de cómo afecta a los humanos.
“Todavía no sabemos cuáles presentaciones clínicas generan estas tres especies recién identificadas, porque no hemos tenido la posibilidad de ver en detalle los expedientes clínicos de los pacientes. No obstante, uno puede anticipar que probablemente intoxiquen otros tipos de células a nivel intestinal y que los receptores pueden ser también un blanco terapéutico porque, si se bloquea el receptor, la toxina no puede entrar en la célula y no la va a intoxicar”, expresó Rodríguez.
LEA MÁS: Vacuna para ‘Clostridium’ se probará en Costa Rica
LEA MÁS: San Juan de Dios implanta heces por ‘Clostridium’
Manos a la obra
Este hallazgo da pie a nuevos estudios. La UCR ya comenzó una investigación de maestría en modelos tanto animales como celulares. Allí se estudiará la virulencia de estos patógenos para compararla con los estudios de la bacteria hermana.
El objetivo es ver si existen diferencias en la patogenicidad, y en cuán agresiva y letal pueda ser. Se sospecha que las tres tendrían menos capacidad para producir una enfermedad.
Esa hipótesis podría tener sentido, pues a la C. difficile le ha tomado millones de años “especializarse” para afectar al ser humano. Las nuevas no son patógenos en sí mismo humanos, son especies ambientales, y no han pasado por todo ese proceso de perfección de la estrategia de la virulencia para enfermar a las personas.
LEA MÁS: Bacterias infectan a 5.000 al año en hospitales de CCSS
